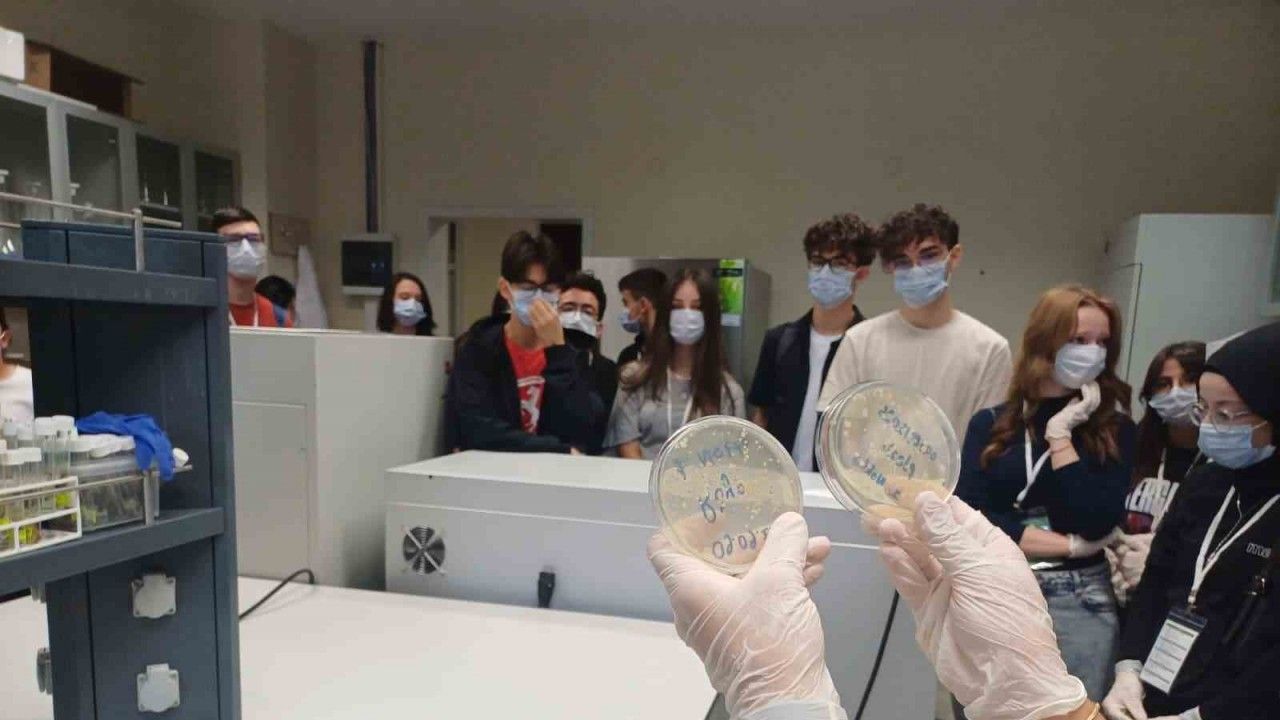

Çankırı’da, lise öğrencileri iklim değişikliğinin etkilerini matematikle hesap yaparak öğrendi. Çalışmayla öğrencilerin iklim değişikliği konusunda farkındalığının arttırılması amaçlanıyor.
Çankırı’da, Ahmet Mecbur Efendi Bilim ve Sanat Merkezi matematik öğretmeni Şeyma Ramazan yürütücülüğünde hayata geçirilen ve TÜBİTAK 4004 Doğa Eğitimi ve Bilim Okulları Destekleme Programı çerçevesinde desteklenen "Matematiğin İzinde Ekosistem" projesiyle öğrenciler ekosistemi matematikle öğrenecek. Milli Eğitim Müdürlüğü ve Çankırı Karatekin Üniversitesi iş birliğiyle yürütülen proje kapsamında, öğrenciler Çankırı Karatekin Üniversitesi Fen Fakültesi laboratuvarlarında çeşitli bilimsel ve eğitsel etkinlikler gerçekleştirdi. Proje süresince katılımcılar, matematiğin ekosistemle olan ilişkisini farklı yönleriyle deneyimleme fırsatı buldu. Daha sonra Alpsarı Göleti’nden alınan örneklerle kuraklık incelendi ve elde edilen veriler laboratuvar ortamında analiz edildi. Uzman akademisyenler ve öğretmenler rehberliğinde yürütülen çalışmalarla öğrencilerin hem matematiksel düşünme becerilerinin geliştirilmesi hem de doğaya karşı farkındalıklarını artırılması hedefledi.
"Ekosistemde matematiğin yerini bir kere daha arkadaşlarımıza anlatmış olacağız"
Projeyle ilgili bilgi veren Çankırı Karatekin Üniversitesi Fen Fakültesi Biyoloji Bölümü Öğretim Üyesi Prof. Dr. Seçil Akıllı Şimşek, "Öğrencilerimize bu çalışmaları matematik ile bağdaştırıp neden önemli olduğunu, matematiğin neden hayatımızda olduğunu anlatmaya çalışıyorum. İlimizde bulunan Alpsarı Göleti’ne giderek incelemeler yaptık. Göletin 4 farklı noktasından su örnekleri aldık. Bunları birlikte inceledik, göletin durumunu değerlendirdik. İklim şartlarından bahsettik. Bunların matematiksel olarak hesabının mikrobiyoloji çalışmaları için önemli olduğunu söyledik. Her bir arkadaşımız her noktadan kendilerine örnek aldılar. Bunları matematiksel olarak yorumlamayı öğrenecekler. Böylece ekosistemde matematiğin yerini bir kere daha arkadaşlarımıza anlatmış olacağız" dedi.
"Bu fırsatı bulduğum için çok mutluyum"
Projeye katılan Çankırı TOBB Fen Lisesi Öğrencisi Rüya Genç ise, "Bu proje bize çok büyük deneyimler kazandırdı. Projeden çok keyif aldık. Bu projede öncelikle Alpsarı Göleti’ne gidip suyun içerisindeki çeşitli bakterilere bakmayı amaçladık. Burada suyun çeşitli özelliklerini ölçümledik. Bakteri örneklerimizi aldık ve yaklaşık 1-2 gün bekleterek inceledik. Bunun için çok heyecanlıyız. Bu fırsatı bulduğum için çok mutluyum" diye konuştu.
"Ana amacımız, yakın gelecekte olacak olan kuraklığa dikkat çekmekti"
Projedeki ana amacın kuraklığa dikkat çekmek olduğunu belirten Çankırı Karatekin Üniversitesi Fen Fakültesi Matematik Bölümü Öğretim Üyesi Doç. Dr. Müfit Şan da, "Bu yaptığımız projede, ilk başta Alpsarı Göleti’nin alanını hesaplattık. Ardından bu gölette gözlemlerde bulunduk. Buradaki ana amacımız kuraklığa dikkat çekmekti. Göletin önceki ve mevcut fotoğraflarını karşılaştırdığımızda bu gölette kuraklığın olduğunu gözlemledik. Matematiksel algoritmalar yardımıyla su alışverişinin yapıldığını gözlemledik. Buradaki ana amacımız, yakın gelecekte olacak olan kuraklığa dikkat çekmekti. Su uzmanlarımız ile görüştük. Onlar da öğrencilerimize gerekli bilgileri verdiler" şeklinde konuştu.